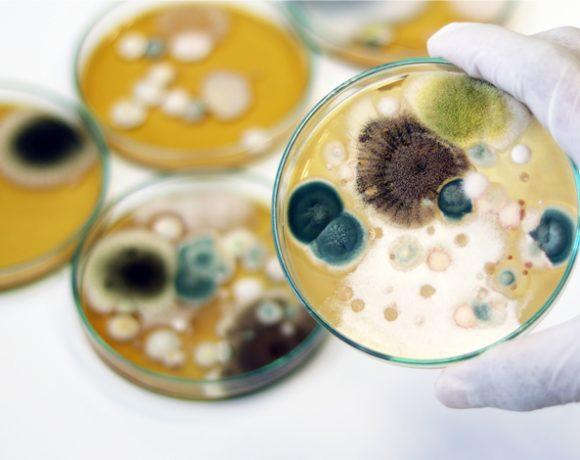

Mold and Bacteria Testing in Naples, Fl
"Protecting Your Space, One Test at a Time: Mold and Bacteria Analysis Experts"

What do we do?
A Company You Can Trust!
"Ensure a mold-free living or working environment by opting for thorough testing instead of mere guesswork, allowing us to accurately assess and address any potential mold issues in your house or office."
- Mold & Bacteria Testing
- Indoor Allergen Testing
- VOC Testing ( Volatile Organic Compound )
- Water Damage
- Insurance Inspection
- PRV ( Post Remediation Verification )